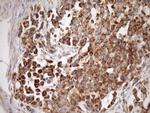
STOML2 Antibody in Immunohistochemistry (Paraffin) (IHC (P))

Search
OriGene
STOML2 Monoclonal Antibody (OTI1F5), TrueMAB™
{{$productOrderCtrl.translations['antibody.pdp.commerceCard.promotion.promotions']}}
{{$productOrderCtrl.translations['antibody.pdp.commerceCard.promotion.viewpromo']}}
{{$productOrderCtrl.translations['antibody.pdp.commerceCard.promotion.promocode']}}: {{promo.promoCode}} {{promo.promoTitle}} {{promo.promoDescription}}. {{$productOrderCtrl.translations['antibody.pdp.commerceCard.promotion.learnmore']}}
产品信息
TA808234
种属反应
宿主/亚型
分类
类型
克隆号
抗原
偶联物
形式
浓度
规格
纯化类型
保存液
内含物
保存条件
运输条件
靶标信息
Mitochondrial protein that probably regulates the biogenesis and the activity of mitochondria. Stimulates cardiolipin biosynthesis, binds cardiolipin-enriched membranes where it recruits and stabilizes some proteins including prohibitin and may therefore act in the organization of functional microdomains in mitochondrial membranes. Through regulation of the mitochondrial function may play a role into several biological processes including cell migration, cell proliferation, T-cell activation, calcium homeostasis and cellular response to stress. May play a role in calcium homeostasis through negative regulation of calcium efflux from mitochondria. Required for mitochondrial hyperfusion a pro-survival cellular response to stress which results in increased ATP production by mitochondria. May also regulate the organization of functional domains at the plasma membrane and play a role in T-cell activation through association with the T-cell receptor signaling complex and its regulation.
仅用于科研。不用于诊断过程。未经明确授权不得转售。
篇参考文献 (0)
生物信息学
蛋白别名: EPB72-like 2; EPB72-like protein 2; Paraprotein target 7; Paratarg-7; SLP-2; stomatin (EPB72)-like 2; stomatin-like protein 2; Stomatin-like protein 2, mitochondrial; unnamed protein product
基因别名: HSPC108; SLP-2; SLP2; STOML2
UniProt ID: (Human) Q9UJZ1
Entrez Gene ID: (Human) 30968